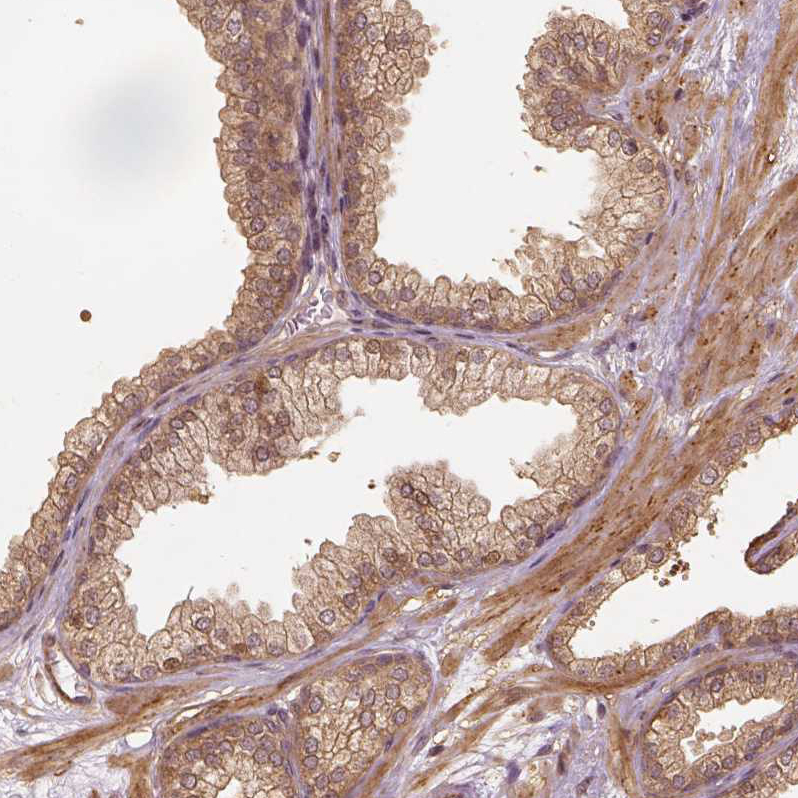

All products are designed for the highest possible performance and are manufactured using a standardized process to ensure the most rigorous levels of quality.
The Anti‑VEGFA antibody (HPA069116) is a high‑quality, reliable tool for detecting VEGFA, the central driver of angiogenesis—blood vessel formation essential for tumor growth, vascular development, and tissue repair. VEGFA is heavily upregulated in cancer, promoting tumor vascularization and suppressing antitumor immune responses, making it a critical target in oncology research.
Significance in Research: This antibody is ideal for studies focused on cancer progression, tumor hypoxia, angiogenesis pathways, and therapeutic response. VEGFA is one of the most extensively studied angiogenic molecules and the primary target of FDA‑approved anti‑angiogenic drugs used in both cancer and ocular disease, underscoring its scientific and clinical importance. Use this antibody to advance your research in vascular biology, oncology, inflammation, and regenerative medicine, with confidence in specificity and performance.
Corresponding antigens
With Atlas Antibodies you get

From our facilities in Stockholm, Sweden we develop, manufacture and distribute highly advanced reagents to the Life Sciences community worldwide.

Our products are available to customers worldwide. From most locations, you can order our products from Atlas Antibodies. Please see more information about how to order here.

Learn how we validate our antibodies, how we secure their reproducibility, and why we apply enhanced validation. Our antibodies are validated in IHC, ICC-IF, and WB.